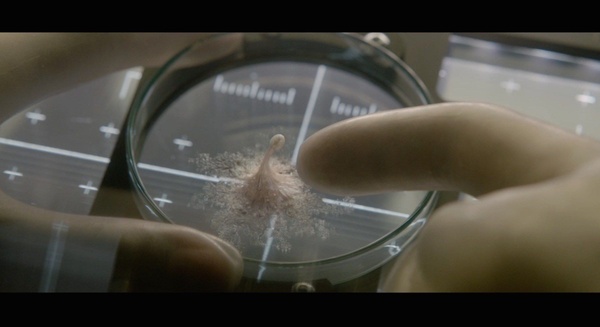
Life - Non oltrepassare il limite

Life - Non oltrepassare il limite
Il lungo piano sequenza iniziale di Life - Non Oltreppassare il Limite è assolutamente nitido. In quella lunga sequenza pensata e girata da Daniel Espinosa ( Safe House, Child 44) c’è un retrogusto di Gravity che è davvero difficile non percepire. Di fatto, sotto questo aspetto, il film è il primo, vero, grande prodotto che si confronta con un post-Gravity. Un passaggio difficile, sicuramente, ma necessario e obbligatorio.
Tuttavia questo Life non è solamente Gravity, ma una vera e propria ratatouille di film che hanno segnato epoche e generi: ci sono piccolissimi rimandi a 2001: Odissea nello Spazio ma più di ogni altra cosa, il cuore di questa esperienza audiovisiva, è senza ombra di dubbio l’Alien di Ridley Scott.
Una scelta tanto importante quanto rischiosa, soprattutto a distanza di pochissime settimane dall’uscita di Alien: Covenant. Come se la saranno cavata attori e regista? Ve lo diciamo nella nostra recensione.
La paura dell’ignoto
La storia ci racconta di questo gruppo di scienziati che da tempo gravitano intorno all’orbita terreste, all’interno di una stazione di ricerca spaziale. Scienziati comuni, semplici, senza velleità guerrafondaie o particolari addestramenti da integerrimi marines. Il loro compito, se vogliamo, è più elevato: studiare campioni di terreno che proviene da Marte.
La svolta si verifica nel momento in cui una sonda riesce a portare a bordo un organismo unicellulare, dimostrando che, anche sul pianeta rosso, c’è vita. Dopo l’euforia generale, l’eccessiva curiosità umana porterà questo organismo a sentirsi minacciato dai continui stimoli, costringendolo a reagire con una forza inaspettata, impetuosa ma soprattutto terrificante.
Da qui inizierà una vera e propria missione per gli astronauti/scienziati: salvarsi ed evitare di che questo organismo (che nel corso del film viene chiamato “Calvin”) arrivi sulla terra.
Nella sua sostanza (e non certamente nella forma), Calvin ci ha ricordato tantissimo gli xenomorfi di Ridley Scott. Se però da una parte abbiamo il senso di minaccia che si poteva percepire anche sulla Nostromo, qui la paura e l’ansia sono maggiori, perché ci troviamo davanti un organismo quasi impercettibile, ma dal potere devastante.

Una grande chance, quindi, quella nelle mani di Espinosa, che purtroppo non riesce a sfruttare a pieno. Il film ha un sicuramente alcuni pregi ma anche un difetto piuttosto evidente. Da una parte troviamo una realizzazione tecnica di tutto rispetto; i sessanta milioni di budget sono stati sfruttati al meglio fino all’ultimo centesimo, e questo ha permesso al regista di creare un impatto visivo importante ed efficace, aiutato inoltre da un cast di buonissimo livello e che conta nomi come quelli di: Ryan Reynolds, Jake Gyllenhall e Rebecca Ferguson.
Di contro abbiamo una storia che rimane sulla superficie del terrore e dell’ansia, e nel suo non annoiare (difficile possa accadere in un prodotto del genere) non approfondisce nulla, si aggrappa a cliché e situazioni a tratti quasi banali, ma soprattutto non riesce a spiegare i motivi di alcune decisioni che vengono prese all’interno del film. Unica eccezione, un finale efficace e che a noi è particolarmente piaciuto.
La rabbia c’è, alla fine della pellicola. La percepiamo come gli attori percepiscono “Calvin” dentro di loro. Quella di Espinosa è stata una grandissima opportunità che poteva essere sfruttata decisamente meglio, e senza troppa fatica. Quello che rimane, invece, è un film onesto, godibile e che non annoia per tutta la durata; una pellicola che potrebbe persino soddisfare i palati di amanti dell’horror spaziale senza particolari pretese.
Bisogna però dire una cosa. Nonostante le sbavature di questo Life, il post Gravity, per quanto riguarda i film a gravità zero, poteva iniziare decisamente peggio, e invece ci troviamo davanti ad un lungometraggio imperfetto nel suo insieme, ma efficace e di impatto dal punto di vista visivo.



